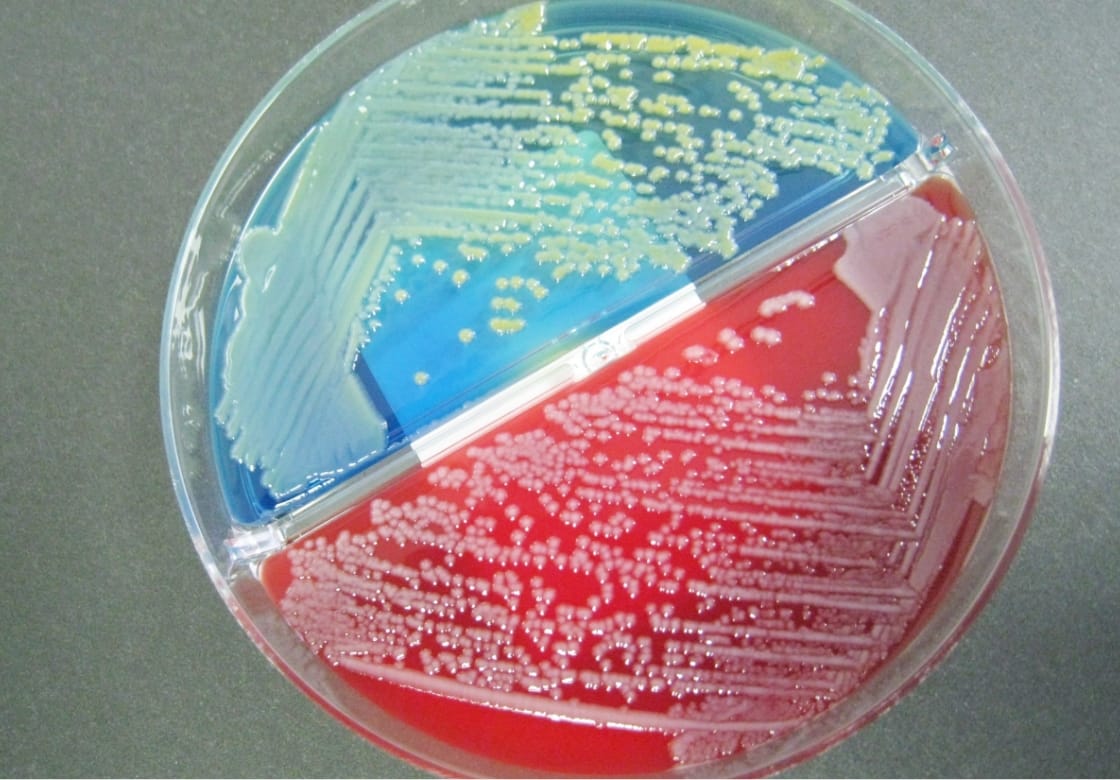

臨床検査科は、血液・尿などの検査を行う「検体検査」、心電図検査や超音波検査などを行う「生理検査」、臓器や細胞の検査を行う「病理検査」、感染症の検査を行う「細菌検査」といった専門分野に分かれて業務を行っています。また、中央処置室での採血業務や健診センターでの検査業務にも携わっています。
病院の理念と診療方針のもと、以下の項目を念頭におきながら業務を行っています。
| 資格名称 | 認定団体名 | 取得者数 |
|---|---|---|
| 細胞検査士 | 日本臨床細胞学会 | 6 |
| 国際細胞検査士 | 国際細胞学会 | 3 |
| 超音波検査士 循環器 |
日本超音波医学会 | 2 |
| 超音波検査士 消化器 |
日本超音波医学会 | 3 |
| 超音波検査士 体表臓器 |
日本超音波医学会 | 3 |
| 超音波検査士 健診 | 日本超音波医学会 | 2 |
| 脳神経超音波検査士 | 脳神経超音波学会 | 1 |
| 認定血液検査技師 | 日本検査血液学会 | 2 |
| 認定輸血検査技師 | 日本輸血・細胞治療学会 | 2 |
| 認定臨床 微生物検査技師 |
日本臨床微生物学会他 | 3 |
| 感染制御認定臨床 微生物検査技師 |
日本臨床微生物学会他 |
3 |
| 認定抗酸菌症エキスパート | 日本結核・非結核性抗酸菌症学会 | 1 |
| 認定病理検査技師 | 日本臨床衛生検査技師会 | 2 |
| 認定臨床化学・ 免疫化学精度 保証管理検査技師 |
日本臨床化学会 | 1 |
| 術中脳脊髄 モニタリング認定技師 |
日本臨床神経生理学会 | 1 |
| 乳がん検診従事者 A判定 |
日本乳腺甲状腺超音波医学会 | 3 |
| NST専門療法士 | 日本臨床栄養代謝学会 | 1 |
| 臨床栄養代謝 専門療法士 (肝疾患専門療法士) |
日本臨床栄養代謝学会 | 1 |
| 糖尿病療養指導士 | 日本糖尿病療養 指導士認定機構 |
1 |
| 東北信地域 糖尿病療養指導士 |
東北信地域糖尿病療養指導士育成会 | 1 |
| 北信糖尿病 デバイス インストラクター |
北信糖尿病デバイスインストラクター研究会 | 4 |
| 認定POC コーディネーター |
日本医療検査科学会 | 1 |
| 2級臨床検査士 微生物 |
日本臨床検査医学会,日本臨床検査同学院 | 2 |
| 2級臨床検査士 病理 |
日本臨床検査医学会,日本臨床検査同学院 | 4 |
| 2級臨床検査士 臨床化学 |
日本臨床検査医学会,日本臨床検査同学院 | 1 |
| 2級臨床検査士 血液 |
日本臨床検査医学会,日本臨床検査同学院 | 3 |
| 2級臨床検査士 免疫血清 |
日本臨床検査医学会,日本臨床検査同学院 | 1 |
| 2級臨床検査士 循環生理 |
日本臨床検査医学会,日本臨床検査同学院 | 1 |
| 緊急臨床検査士 | 日本臨床検査医学会,日本臨床検査同学院 | 4 |
| JHRS認定心電図専門士 | 日本不整脈心電学会 | 1 |
| 心電図検定1級 | 日本不整脈心電学会 | 2 |
| 心電図検定2級 | 日本不整脈心電学会 | 3 |
| 心電図検定3級 | 日本不整脈心電学会 | 1 |
| 心電図検定4級 | 日本不整脈心電学会 | 1 |
| 心血管インター ベンション技師 |
日本心血管インターベンション治療学会 | 1 |
| 健康食品管理士 | 日本食品安全協会 | 2 |
| 第一種衛生管理士 | 安全衛生技術試験協会 | 1 |
| 特定化学物質・ 四アルキル鉛等 作業者主任者 |
厚生労働省労働基準局 | 2 |
| 有機溶剤作業主任者 | 厚生労働省労働基準局 | 2 |
| 認定認知症 領域検査技師 |
日本認知症予防学会 日本臨床衛生検査技師会 | 1 |
| 医療安全管理者 | 日本精神科病院協会 | 2 |
| 危険物取扱者乙種4類 | 都道府県知事 | 2 |
| 化学物質管理者 | 厚生労働省労働基準局 | 1 |
| 肝炎医療コーディネーター | 厚生労働省/長野県健康福祉部感染対策課 | 5 |
長野市民病院臨床検査科では、臨床検査の品質および信頼性の向上を目的として、ISO15189の認定取得に向けた取り組みを行っております。
ISO15189申請項目は以下の活動リストをご覧ください。
臨床検査科では様々な検査を行っております。
ご不明な点や不安がございましたら遠慮なくお近くの検査技師にお尋ねください。
また、当院では、採血および生理検査の際、本人確認のため、お名前を名乗っていただいています。
正しい測定条件によって得られた検査結果は、正確な診断や効果的な治療につながります。
以下に示した項目の注意事項をお守りくださるよう、ご協力をお願いいたします。
こちらもお読みください
検体系、病態系、生理系の3部門で構成され、様々な業務を行っております。

中央処置室受付 患者呼込みシステム画面
※順番が来た際に画面でご案内をしています

中央処置室風景
中央処置室では、外来の患者さんを対象として、臨床検査技師が採血、糖負荷試験、出血時間、尿素呼気試験、採尿等、看護師が採血、注射、点滴、一般処置等を実施しております(約270人/1日)。
また採血管準備システムにより、翌日の病棟患者さんの採血管を準備し、配布しています。
採取した検体は、エアシューターで2階の臨床検査室へ送られます。

生化学自動分析装置
生化学検査は、血液や尿中に存在する蛋白、糖、脂質、窒素化合物、微量元素、肝臓や心臓などに含まれている酵素などを測定するもので、これらの成分の増減により、疾患を推定することができます。
導入している自動分析装置(TBA-c16000)は、約60項目の検査が可能で1時間に1800項目を処理します。

免疫自動分析装置
免疫血清検査には、感染症検査(コロナウイルス、肝炎ウイルス、梅毒、HIV)、肝臓、卵巣、大腸、前立腺などの腫瘍マーカー検査、ホルモン等の検査が含まれ、化学発光免疫測定システム(ARCHITECT i2000SR)と免疫発光測定装置(Cobas 6000、LUMIPULSE G600Ⅱ)を使用しています。
また、便潜血検査は便潜血測定装置(OCセンサーDIANA PLEDIA)を導入して実施しております。

全自動尿検査装置
一般検査では、尿や体腔液を用い、主に形態学的な検査を行っています。尿検査では、尿中の蛋白や糖など試験紙を用いて検出します。
また、検体は清明でも細胞や細菌などの有形成分が含まれている場合があり、顕微鏡の観察で腎臓や尿路の異常を見つけることができます。

自動血球分析装置
血液検査では、体内に流れている血液(白血球・赤血球・血小板)の質的及び量的な変化を検査しています。それにより、貧血があるか、白血病の疑いがあるかなどがわかります。
異常が疑われる場合には、血液を造っている骨髄(骨の中にある組織です)の検査を行います。
また、血液が正常に止血するかを調べる血液凝固検査も行っています。

自動輸血検査装置
輸血検査では、輸血する場合に必要となる血液型、不規則抗体(他人の赤血球に対する抗体の有無を調べます)、交差適合試験(輸血される血液との相性を調べます)などの検査業務に加え、血液製剤の在庫管理、出庫業務、輸血副作用の把握など血液製剤の管理的な業務も行っています。
また、自動分析装置(写真)、輸血管理システムや患者認証システムを使用し、より安全な輸血療法が行われるように努めています。

一般細菌検査
培養した細菌

質量分析計
一般細菌検査
提出された検体(尿、痰、便、血液、膿 等)を培養して、感染症の原因となっている菌がどんな菌で、どのような薬が効くかを調べます。
抗酸菌検査
結核菌を代表とする抗酸菌と呼ばれる菌の検査を行っています。塗抹検査(顕微鏡で菌の有無を直接調べる)、培養検査、遺伝子検査(結核菌TRC検査)等を実施しています。
感染症迅速検査
A群溶連菌抗原検査、インフルエンザウイルス抗原検査等、感染症迅速検査を実施しています。
上記業務の他に感染対策室と連携し、耐性菌検出状況の報告を行い、院内感染対策業務に携わっています。

病理標本作成風景

症例検討

病理標本観察診断
病理検査では、臨床医、病理医、臨床検査技師または細胞検査士が連携をとり、組織診断、細胞診断、病理解剖を行っています。

心電図検査

負荷心電図検査

簡易肺機能検査
生理検査室では、外来および入院患者さんを対象に各種検査を行っています。心電図、ホルター心電図、心臓超音波をはじめ、血管超音波、肺機能検査、脳波検査、神経伝導速度検査、聴力検査、血圧脈波検査(ABI)、終夜睡眠ポリグラフィー(PSG)検査などを行っています。
主に患者さんに直接触れて行う検査になります。検査時に疑問点などありましたら、遠慮なくご相談ください。

超音波検査

眼底写真検査

聴力検査
健診センターでは人間ドック受診者の心電図、肺機能検査、眼底写真、聴力検査、血圧脈波検査、腹部超音波、頚動脈超音波、乳腺超音波などを行っています。十分注意して検査を行っていますが、苦痛なことなどありましたら、遠慮なくお伝えください。
| 生化学 | 日本語名 | 基準値 | 単位 | 意義 |
|---|---|---|---|---|
| TP | 総蛋白 | 6.6~8.1 | g/dL | 身体の栄養状態の指標になります。 |
| Alb | アルブミン | 4.1~5.1 | g/dL | |
| Glob | グロブリン | 2.5~3.0 | g/dL | |
| A/G | アルブミン・グロブリン比 | 1.37~2.04 | ||
| T.Bil | 総ビリルビン | 0.4~1.5 | mg/dL | 肝細胞障害で上昇し、黄疸の指標になります。 |
| D.Bil | 直接ビリルビン | 0.1~0.4 | mg/dL | 急性肝炎や総胆管結石などで上昇します。 |
| I.Bil | 間接ビリルビン | 0.1~0.8 | mg/dL | 溶血性疾患や黄疸などで上昇します。 |
| AST | アスパラギン酸トランスアミナーゼ | 13~30 | U/L | 肝臓や心臓の細胞に多く含まれ、その細胞が壊れると高値になります。 |
| ALT | アラニントランスアミナーゼ | 男10~42 | U/L | 特に肝臓の細胞に多く含まれ、細胞が壊れると高値になります。 |
| 女7~23 | ||||
| LD | 乳酸脱水素酵素 | 124~222 | U/L | 肝臓や心臓疾患、血液疾患などで高値になります。 |
| ALP | アルカリフォスファターゼ | 106~322 | U/L | 肝・胆道系・骨疾患などに関係し、子供の成長期にも高値になります。 |
| γ-GTP | ガンマ-グルタミルトランスペプチダーゼ | 男13~64 | U/L | 特にアルコール性の肝障害で上昇します。 |
| 女9~32 | ||||
| ChE | コリンエステラーゼ | 男240~486 | U/L | 肝障害で低値になります。 |
| 女201~421 | ||||
| AMY | アミラーゼ | 44~132 | U/L | 膵炎、耳下腺炎などで上昇します。 |
| P-AMY | 膵型アミラーゼ | 22~55 | U/L | 総アミラーゼのうち、膵臓に由来するものです。 |
| CK | クレアチンキナーゼ | 男59~248 | U/L | 筋肉・心臓・脳に含まれる酵素で筋・心臓疾患などで上昇します。 |
| 女41~153 | ||||
| CK-MB(mass) | シーケイ・エムビー | < 5 | U/L | 特に心筋梗塞で高値になります。 |
| TC | 総コレステロール | 142~248 | mg/dL | 動脈硬化の危険因子です。 |
| TG | 中性脂肪 | 男40~234 | mg/dL | 食事により大きく変動し、動脈硬化の危険因子になります。 |
| 女30~117 | ||||
| HDL-C | HDLコレステロール | 男 38~90 | mg/dL | 善玉コレステロールとも言われ、低値ほど動脈硬化になり易くなります。 |
| 女 48~103 | ||||
| LDL-C | LDLコレステロール | 65~163 | mg/dL | 悪玉コレステロールとも言われ、動脈硬化の危険因子です。 |
| UN | 尿素窒素 | 8~20 | mg/dL | 食事によっても変動し、腎機能障害で上昇します。 |
| Cre | クレアチニン | 男 0.65~1.07 | mg/dL | 腎機能障害で上昇します。 |
| 女 0.46~0.79 | ||||
| UA | 尿酸 | 男 3.7~7.8 | mg/dL | 血中に増え過ぎると痛風の原因になります。 |
| 女 2.6~5.5 | ||||
| Na | ナトリウム | 138~145 | mmol/L | 脱水などで高値になります。 |
| K | カリウム | 3.6~4.8 | mmol/L | 腎臓機能障害などで上昇します。 |
| Cl | クロール | 101~108 | mmol/L | 水分代謝異常の指標になります。 |
| Ca | カルシウム | 8.8~10.1 | mg/dL | 副甲状腺ホルモン、骨代謝、腎機能などの影響を受けて変動します。 |
| IP | 無機リン | 2.7~4.6 | mg/dL | 血中カルシウム濃度の変動と関係があります。 |
| CRP | C反応性蛋白 | < 0.14 | mg/dL | 炎症が有ると増加します。 |
| Fe | 血清鉄 | 40~188 | μg/dL | 鉄欠乏性貧血などで低値になります。 |
| IgG | 免疫グロブリンG | 861~1747 | mg/dL | 細菌などの感染から体を守るタンパクです。 |
| IgA | 免疫グロブリンA | 93~393 | mg/dL | |
| IgM | 免疫グロブリンM | 男 33~183 | mg/dL | |
| 女 50~269 | ||||
| C3 | 補体第3成分 | 73~138 | mg/dL | 自己免疫疾患・感染症の指標です。 |
| C4 | 補体第4成分 | 11~31 | mg/dL | |
| UIBC | 不飽和鉄結合能 | 男 104~259 | μg/dL | 鉄を運ぶ蛋白に、結合が可能な鉄量で、貧血では増加します。 |
| 女 108~325 | ||||
| TIBC | 総鉄結合能 | 男 253~365 | μg/dL | 鉄と不飽和鉄結合能の総和です。 |
| 女 246~410 | ||||
| Glu | グルコース | 73~109 | mg/dL | 血液中のブドウ糖濃度で、糖尿病の診断に用いられています。 |
| 血糖 | 血糖 | 73~109 | mg/dL | |
| HbA1c | ヘモグロビンエーワンシー | 4.9~6.0 | % | 約2ヶ月間の平均的な血糖値を反映します。 |
| GA | グリコアルブミン | 12.3~16.5 | % | 約2週間の平均的な血糖値を反映します。 |
| アンモニア | アンモニア | 6.0~51.0 | μg/dL | 肝障害で上昇します。 |
| Troponin T | トロポニン ティー | < 0.10 | ng/mL | 心筋梗塞で陽性になります。 |
| 血液 | 日本語名 | 基準値 | 単 位 | 意 義 |
|---|---|---|---|---|
| WBC | 白血球数 | 3300~8600 | /μl | 細菌やウイルスの感染や炎症などで増加します。 |
| RBC | 赤血球数 | 男 435~555 | 104/μl | 貧血、多血症、脱水の指標になります。 |
| 女 386~492 | ||||
| HGB | 血色素量(ヘモグロビン) | 男 13.7~16.8 | g/dl | |
| 女 11.6~14.8 | ||||
| HCT | ヘマトクリット | 男 40.7~50.1 | % | |
| 女 35.1~44.4 | ||||
| MCV | 平均赤血球容積 | 83.6~98.2 | fl | 赤血球の平均的な体積です。 |
| MCH | 平均赤血球血色素量 | 27.5~33.2 | pg | 赤血球中のヘモグロビン量です。 |
| MCHC | 平均血球血色素濃度 | 31.7~35.3 | % | 赤血球中のヘモグロビン濃度を比率で表した数値です。 |
| PLT | 血小板数 | 15.8~34.8 | 104/μl | 止血に関与する血小板の数で、出血や血栓に関係します。 |
| RET-C | 網赤血球数 | 男 3.0~9.4 | 104/μl | 幼若な赤血球の数です。 |
| 女 2.2~8.3 | ||||
| RET% | 網赤血球率 | 男 0.7~1.9 | % | 幼若な赤血球の比率で、赤血球産生能の指標となります。 |
| 女 0.6~2.1 | ||||
| IPF | 幼若血小板指数 | 0.5~5.3 | % | 幼若な血小板の比率で、血小板産生能の指標となります。 |
| %RP | 網血小板比率 | 0.2~5.4 | % | |
| 白血球分類 | 日本語名 | 基準値 | 単 位 | 意 義 |
| NEUTRO | 好中球 | 男 41.2~74.7 | % | 感染症などで増加します。 |
| 女 38.3~71.1 | ||||
| LYMPHO | リンパ球 | 男 21.2~51.0 | % | 免疫に関係し、細菌やウイルス感染で増加します。 |
| 女 21.3~50.2 | ||||
| MONO | 単球 | 男 3.1~8.0 | % | 免疫に関する働きを持っています。 |
| 女 2.7~7.6 | ||||
| EOSINO | 好酸球 | 男 0.2~8.4 | % | アレルギー性疾患、寄生虫感染で増加します。 |
| 女 0.2~7.3 | ||||
| BASO | 好塩基球 | 男 0.2~1.8 | % | 炎症が有る場合に変動します。 |
| 女 0.2~2.0 | ||||
| 凝固 | 日本語名 | 基準値 | 単 位 | 意 義 |
| PT sec | プロトロンビン時間 | 11.0~14.0 | sec | |
| PT % | プロトロンビン濃度 | 80~120 | % | 凝固因子の欠損症、肝障害、 |
| PT-R | プロトロンビン比 | 0.85~1.15 | ||
| PT-INR | 国際標準比 | 0.85~1.15 | 経口抗凝固薬の服用時に変動します。 | |
| APTT | 活性化部分トロンボプラスチン時間 | 24.0~34.0 | sec | 凝固因子の減少や異常により延長します。 |
| Fib | フィブリノーゲン | 200~400 | mg/dl | 血液凝固に関係し、低値では出血傾向が出現します。 |
| ATIII | アンチトロンビンⅢ | 80~130 | % | 血管内凝固や血栓形成の抑制因子です。 |
| FDP | フィブリン分解産物 | < 5.0 | μg/ml | フィブリノーゲンやフィブリンの分解産物で、血栓症などで増加します。 |
| D ダイマー | ディー ダイマー | < 1.0 | μg/ml | 血管内に形成された血栓の程度を反映します。 |
| 尿一般 | 日本語名 | 基準値 | 単 位 | 意 義 |
|---|---|---|---|---|
| pH | ペーハー | 5.0~7.5 | 尿路感染などで高くなります。 | |
| 比重 | 1.005~1.030 | 腎臓の濃縮能をみるための指標になります。 | ||
| 蛋白 | - | 腎臓の炎症や発熱時などで陽性になります。 | ||
| 糖 | - | 糖尿病などで陽性になります。 | ||
| ケトン体 | - | 高熱、飢餓状態、嘔吐、下痢等の場合に陽性になります。 | ||
| ビリルビン | - | 肝障害などで陽性になります。 | ||
| 潜血 | - | 腎臓、膀胱、尿路などに異常が有ると認められます。 | ||
| 亜硝酸塩 | - | 細菌による尿路感染が有ると陽性になります。 | ||
| ウロビリノーゲン | 0.1~1.0 | mg/dl | 溶血性貧血、肝炎などで陽性を呈します。 | |
| 白血球 | - | 細菌などの感染症で増加します。 | ||
| 色調 | - | 食物、発汗などの影響により変化します。 | ||
| 混濁 | - | 結晶成分や上皮、細菌などが多い場合に陽性となります。 | ||
| 尿沈渣 | ||||
| 赤血球 | <1/F | 腎臓、膀胱、尿路に出血性の病変がある場合に認められます。 | ||
| 白血球 | 男 <1/F | 腎臓、膀胱、尿路に炎症が有ると尿中に多く認められます。 | ||
| 女 <4/F | ||||
| 細菌 | - | 腎臓、膀胱、尿路に細菌が繁殖した場合に多く認められます。 | ||
| 便検査 | 日本語名 | 基準値 | 単 位 | 意 義 |
| 潜血(免疫) | - | 消化管の出血で陽性となります。 | ||
全自動生化学自動分析装置(TBA-c16000)、全自動生化学自動分析装置(TBA-25FR)、全自動化学発光免疫測定装置(ARCHITECT i2000SR)、免疫生化学統合分析装置(Atellica)、全自動血糖分析(GA09Ⅱ)、全自動グリコヘモグロビン分析計(HLC-723 G11)、免疫自動分析装置(cobas601/501、cobas e411)、全自動キャピラリー電気泳動システム(Minicap Flex Piercing)、全自動尿中有形成分分析装置(UF-1000i)、エンドトキシン測定システム(トキシノメーターmt5500)、全自動尿分析装置(オーションマックス AX-4060)、全自動蛍光免疫測定装置(ミュータス ワコー)、肝臓機能血清中濃度測定装置(ICGメータ)、便潜血測定装置(OC SENSOR)、呼気中CO2分析装置(POC one)、自動浸透圧分析装置(オスモステーション)、血中アンモニア測定専用装置(DRI-CHEM NX10N)
血小板凝集能測定装置(PRP313M)、全自動凝固測定装置(CP3000、CP2000)、全自動血液分析装置(XN3000)、全自動血球計数装置(CELLDYN Sapphire)、血液ガス分析装置(ABL825)、全自動輸血検査装置(VISION)、赤血球沈降速度分析装置(Monitor20)、全自動輸血検査装置(VISION)
微生物分類同定分析装置(バイテックMS Plus)、全自動細菌同定感受性検査装置(バイテック2ブルー)、微生物感受性分析装置(DPS192iX)、全自動血液培養検査装置(バーサトレック384モデル)、全自動遺伝子検査装置(TRCReady-80)
自動染色装置(Leica Autostainer XL)、自動免疫染色装置(VENTANA BenchMark ULTRA)、感染防止機能付凍結組織切片作成装置(Leica CM1950)、密閉式自動固定包埋装置(Tissue-Tek VIP 6AI)、OSNAR法遺伝子増幅検出装置 (Sysmex RD-100i) 、バーチャルスライドシステム(Olympus VS-100)
リアルタイム定量PCRシステム(LC96IP)、遺伝子解析装置(AutoAmp)
心電計(cardiosoft、MAC 5500)、加算心電計(MAC 5500)、心臓超音波診断装置(EPIQ7、EPIQ5、ARIETTA 850、IE33)、心臓カテーテルポリグラフ(RMC‐4000)、トレッドミル運動負荷装置(CASE ADVANCE)、呼吸機能検査装置(D-21 FXⅢ)、精密肺機能検査装置(CHESTAC 8800)、オージオメータ(AA-HI)、インピーダンスオージオメータ(RS―22)、脳波計(Neurofax 1218、1214)、筋電図・誘発電位検査装置(Neuropack X1)、ホルター心電計(RAC-2503、RAC-2512)、イベントホルター心電計(CG-6106)、血圧脈波測定装置(VS-1000)、体成分分析装置(In Body S10)、平衡機能検査装置(NY-20)、終夜睡眠ポリグラフィー検査装置(スリープウォッチャーE)、肺運動負荷モニタリングシステム(Cpex-1)
心電計(cardiosoft)、肺機能検査装置(D-21 FXⅢ)、オージオメータ(AA-56)、デジタル眼底カメラ(CR-2PLUUS AF)、血圧脈波測定装置(VS-1500)、腹部超音波診断装置(Aplio a450、Aplio、Avius)
NST介入患者さんの身体計測、検査値から見た低栄養入院患者リストの提示、栄養評価指標の情報処理、検査データの解析および追加すべき検査の提唱などを行っております。
なにをお探しですか?
